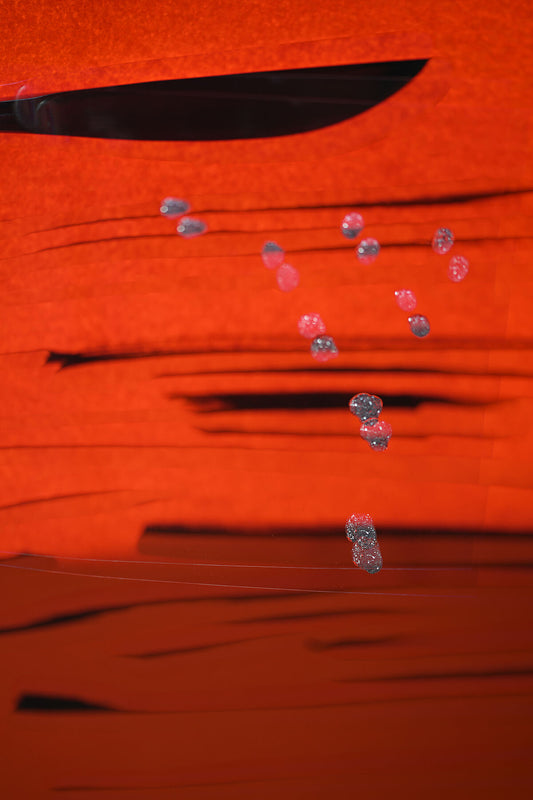

Collection: personal development
We all know that if we want to grow spiritually, we must first focus on our personal development. But sometimes it's hard to stay motivated on our path. That's where pictures like these come in! They serve as reminders and sources of inspiration to help us stay on track and continue to evolve. Whether you're looking for a daily dose of motivation or just something to spur you on your growth path, these powerful images are sure to help!
-
"Triad of a Mason" – Freemason mug with symbolic character
Regular price €19,95 EURRegular price -
The Blessing Cup – A Vessel Full of Faith, Love, and Hope (English Language)
Regular price €19,95 EURRegular price -
The Blessing Cup - A cup full of faith, love and hope
Regular price €19,95 EURRegular price -
Vastness - ocean of life
Regular price From €85,95 EURRegular price -
Energy in blue and red
Regular price From €85,95 EURRegular price -
the complexity of red
Regular price €238,95 EURRegular price -
The Longing of the Soul
Regular price From €85,95 EURRegular price -
burning light
Regular price From €85,95 EURRegular price -
calm - haiku
Regular price From €85,95 EURRegular price